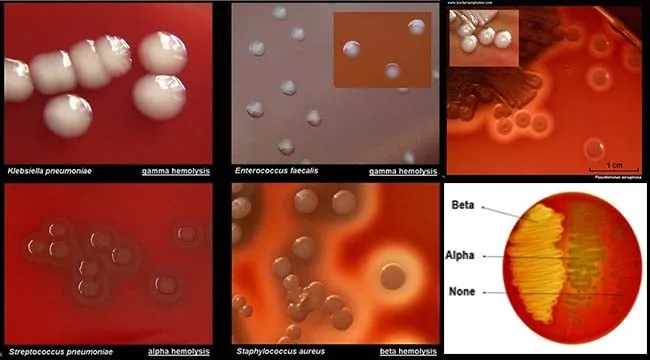
Bacterial colonies showing different morphologies on blood agar plate

Diagnostic microbiology transforms invisible threats into actionable intelligence, bridging the gap between a patient's symptoms and life-saving treatment. You'll master the complete diagnostic pathway-from precise specimen collection that preserves pathogen viability, through culture techniques that coax organisms into visibility, to rapid tests that deliver answers in minutes rather than days. You'll decode antimicrobial susceptibility patterns that guide therapy, harness molecular methods that identify pathogens by their genetic fingerprints, and integrate these tools into clinical decision-making that changes outcomes. This is detective work at the microscopic scale, where your technical precision and interpretive skill directly determine whether antibiotics hit their mark.

📌 Remember: CLSI - Clinical Laboratory Standards Institute guidelines govern 95% of diagnostic microbiology protocols worldwide
The diagnostic journey begins with specimen collection and progresses through multiple analytical phases, each requiring specific technical expertise and quality control measures. Modern laboratories integrate traditional culture methods with rapid molecular diagnostics, creating comprehensive pathogen detection systems.
| Diagnostic Method | Time to Result | Sensitivity | Specificity | Cost Factor | Clinical Application |
|---|---|---|---|---|---|
| Culture Methods | 24-72 hours | 90-95% | >99% | Low | Gold standard identification |
| Rapid Antigen | 15-30 minutes | 70-85% | 95-99% | Medium | Point-of-care screening |
| Molecular PCR | 2-6 hours | 95-99% | 98-100% | High | Rapid definitive diagnosis |
| MALDI-TOF MS | 5-15 minutes | 85-95% | >95% | Medium | Rapid organism identification |
| Automated Systems | 4-18 hours | 90-98% | 95-99% | High | High-throughput processing |
💡 Master This: Every diagnostic decision depends on understanding the analytical sensitivity (10²-10⁴ CFU/mL detection limits) versus clinical sensitivity (correlation with disease presence) for each testing methodology
The integration of traditional and molecular methods creates diagnostic algorithms optimized for specific clinical scenarios. Understanding these workflows enables clinicians to select appropriate testing strategies and interpret results within proper clinical context.

📌 Remember: CLOT - Clean site, Label properly, Optimal volume, Transport quickly for successful specimen processing
Specimen collection requires understanding pathogen-specific requirements, anatomical site considerations, and timing relationships with clinical presentation. Each specimen type demands specific collection techniques, transport media, and processing timelines to maintain organism viability and diagnostic accuracy.
| Specimen Type | Collection Volume | Transport Medium | Temperature | Time Limit | Critical Success Factor |
|---|---|---|---|---|---|
| Blood Culture | 20-30 mL total | Culture bottles | Room temp | <4 hours | Sterile technique |
| CSF | 2-5 mL | Sterile container | Room temp | <1 hour | Immediate processing |
| Wound/Abscess | 1-2 mL pus | Anaerobic transport | Room temp | <2 hours | Anaerobic preservation |
| Stool | Walnut-sized | Enteric transport | Room temp | <2 hours | Mucus/blood inclusion |
| Genital | Swab saturation | Specific transport | Room temp | <2 hours | Anatomical site accuracy |
💡 Master This: Understanding pre-analytical variables (collection timing, transport conditions, specimen adequacy) prevents 60-80% of diagnostic errors and false-negative results
Transport conditions critically affect organism viability and diagnostic accuracy. Different pathogens require specific environmental conditions, with fastidious organisms showing rapid viability loss under suboptimal transport conditions.
The specimen collection phase establishes the foundation for all subsequent diagnostic steps, where technical precision directly correlates with clinical diagnostic accuracy and patient care optimization.
📌 Remember: MAGIC - Media selection, Atmosphere control, Growth monitoring, Incubation timing, Colony characterization for successful culture
Media selection requires understanding nutritional requirements, selective properties, and differential characteristics for target organisms. Each pathogen group demands specific growth conditions, with fastidious organisms requiring enriched media and controlled atmospheric conditions.
| Media Type | Primary Use | Key Components | Incubation | Expected Growth | Diagnostic Yield |
|---|---|---|---|---|---|
| Blood Agar | General purpose | 5% sheep blood | 35°C, 18-24h | Most bacteria | 90-95% |
| Chocolate Agar | Fastidious organisms | Heated blood | 35°C, CO₂ | Haemophilus, Neisseria | 85-90% |
| MacConkey | Gram-negative selection | Bile salts, lactose | 35°C, 18-24h | Enterobacteriaceae | 95-98% |
| Mannitol Salt | Staphylococcus selection | 7.5% NaCl | 35°C, 24-48h | Staphylococci | 90-95% |
| Anaerobic Blood | Anaerobic bacteria | Reduced media | 35°C, 48-72h | Anaerobes | 80-85% |
💡 Master This: Understanding growth kinetics (lag phase 2-4 hours, log phase 4-12 hours, stationary phase >12 hours) enables optimal colony selection timing for accurate identification
Quality control measures ensure culture system reliability and diagnostic accuracy. Daily monitoring of media performance, incubator conditions, and growth controls maintains system integrity and prevents false-negative results.
Culture methodology provides the foundation for antimicrobial susceptibility testing and serves as the reference standard against which all rapid diagnostic methods are validated.
📌 Remember: RAPID - Reliable results, Accurate detection, Point-of-care capability, Immediate action, Decision support for clinical excellence
Rapid diagnostic technologies encompass immunochromatographic assays, molecular amplification methods, and automated identification systems. Each technology offers specific advantages for different clinical scenarios, with performance characteristics varying by pathogen type and specimen source.
| Technology | Time to Result | Sensitivity | Specificity | Targets per Test | Clinical Application |
|---|---|---|---|---|---|
| Antigen Tests | 5-15 minutes | 80-95% | 95-99% | 1-2 | Point-of-care screening |
| Molecular Panels | 1-6 hours | 95-99% | 98-100% | 15-25 | Syndromic diagnosis |
| MALDI-TOF | 2-5 minutes | 85-95% | >95% | ID only | Rapid identification |
| Automated AST | 4-18 hours | 90-98% | 95-99% | 15-20 drugs | Resistance detection |
| Biosensors | 30-60 minutes | 85-95% | 90-98% | 1-5 | Critical care monitoring |
💡 Master This: Understanding analytical sensitivity versus clinical sensitivity prevents over-reliance on rapid tests with detection limits that may miss low-level infections requiring culture confirmation
Cost-effectiveness analysis demonstrates rapid testing value through reduced length of stay, optimized antibiotic use, and improved patient outcomes. Integration with antimicrobial stewardship programs maximizes clinical impact while controlling healthcare costs.

Rapid diagnostics complement rather than replace traditional culture methods, creating comprehensive diagnostic algorithms that optimize both speed and accuracy for superior patient care.

📌 Remember: CLEARS - Clinical breakpoints, Laboratory standards, Error detection, Accuracy controls, Resistance mechanisms, Stewardship support
Susceptibility testing employs multiple methodologies, each with specific applications, performance characteristics, and clinical utility. Understanding method selection criteria and result interpretation enables optimal integration of susceptibility data with clinical decision-making processes.
| Method | Result Type | Time Required | Cost per Test | Automation Level | Clinical Application |
|---|---|---|---|---|---|
| Disk Diffusion | Zone diameter | 18-24 hours | $2-3 | Manual reading | Routine screening |
| Broth Microdilution | MIC value | 16-20 hours | $5-8 | Automated | Precise dosing |
| Gradient Strip | MIC value | 18-24 hours | $8-12 | Manual reading | Fastidious organisms |
| Rapid Systems | MIC/Category | 4-8 hours | $10-15 | Fully automated | Critical infections |
| Molecular | Gene detection | 2-6 hours | $15-25 | Automated | Resistance prediction |
💡 Master This: Understanding pharmacokinetic/pharmacodynamic relationships enables interpretation of MIC values relative to achievable tissue concentrations for optimal therapeutic outcomes
Resistance mechanism detection enhances susceptibility testing by identifying specific resistance genes and predicting phenotypic resistance patterns. Molecular methods provide rapid resistance detection, particularly for slow-growing organisms and critical resistance markers.

Quality assurance programs ensure susceptibility testing accuracy through daily control strain testing, proficiency testing participation, and systematic error detection protocols that maintain clinical reliability.
📌 Remember: PRIMER - Pathogen targets, Resistance genes, Identification speed, Multiplex capability, Error prevention, Result validation
Molecular methods encompass various amplification technologies, each offering specific advantages for different clinical applications. Understanding technology selection criteria and performance characteristics enables optimal test utilization for diverse diagnostic scenarios.
| Technology | Targets per Test | Time to Result | Sensitivity | Quantitative | Clinical Application |
|---|---|---|---|---|---|
| Real-time PCR | 1-4 | 2-4 hours | 95-99% | Yes | Targeted detection |
| Multiplex PCR | 15-25 | 1-6 hours | 90-98% | Limited | Syndromic panels |
| LAMP | 1-3 | 30-60 minutes | 85-95% | No | Point-of-care |
| Sequencing | Unlimited | 24-48 hours | >95% | Yes | Unknown pathogens |
| Microarray | 50-100 | 4-8 hours | 90-95% | No | Resistance profiling |
💡 Master This: Understanding analytical sensitivity (copies/mL) versus clinical sensitivity (correlation with disease) prevents over-interpretation of positive molecular results in asymptomatic patients
Molecular testing limitations include inability to assess organism viability, potential for contamination, and requirement for antimicrobial susceptibility testing by alternative methods. Integration with culture methods provides comprehensive diagnostic approaches combining speed with complete therapeutic guidance.
Quality control measures for molecular testing include extraction controls, amplification controls, and inhibition monitoring to ensure accurate results and prevent false-negative reporting due to technical failures.
📌 Remember: IMPACT - Integrated results, Multiple methods, Patient correlation, Antibiotic guidance, Clinical outcomes, Timing optimization
Clinical integration requires understanding the complementary roles of different diagnostic methods, their relative strengths and limitations, and optimal sequencing for specific clinical scenarios. Effective integration maximizes diagnostic accuracy while optimizing resource utilization and patient care efficiency.
| Clinical Scenario | Primary Method | Confirmatory Test | Time to Action | Diagnostic Accuracy | Cost Optimization |
|---|---|---|---|---|---|
| Sepsis Workup | Blood culture + Rapid PCR | Susceptibility testing | 2-6 hours | >95% | 30-40% reduction |
| Pneumonia Diagnosis | Respiratory culture + Antigen | Molecular panel | 4-24 hours | 90-95% | 25-35% reduction |
| UTI Evaluation | Urine culture + Rapid screen | Automated susceptibility | 1-18 hours | >98% | 40-50% reduction |
| Wound Infection | Culture + Gram stain | Anaerobic culture | 18-72 hours | 85-95% | 20-30% reduction |
| Meningitis Workup | CSF culture + Molecular | Antigen detection | 1-24 hours | >95% | High priority |
💡 Master This: Understanding diagnostic stewardship principles enables optimal test selection that maximizes clinical value while minimizing unnecessary testing and healthcare costs
Quality metrics for diagnostic integration include turnaround time monitoring, clinical correlation assessment, and outcome tracking to ensure optimal patient care delivery. Continuous improvement processes optimize diagnostic workflows and enhance clinical decision support capabilities.

Effective diagnostic integration requires multidisciplinary collaboration between laboratory professionals, clinicians, and antimicrobial stewardship teams to optimize patient outcomes through evidence-based diagnostic and therapeutic decision-making.
Have doubts about this lesson?
Ask Rezzy, our AI tutor, to explain anything you didn't understand
Test your understanding with these related questions
Which of the following attributes are essential for an ideal screening test?